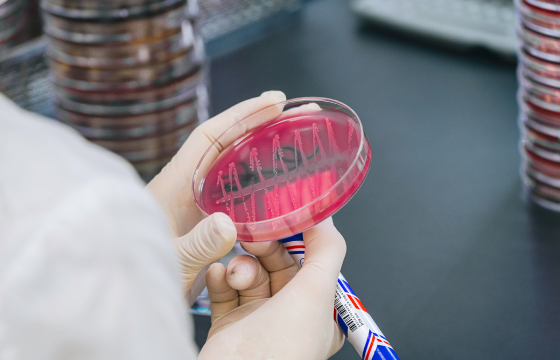

진단검사의학과


진단검사의학과는 환자의 정확한 진단을 위해 혈액, 소변, 체액 등 인체에서 유래하는 각종 검체를 분석하고 판독하여 질병의 진단 및 감별, 중등도 및 경과를 파악하고 치료 방향 결정과 예후 판정에 매우 중요한 역할을 담당하고 있습니다.
삼광의료재단은 최첨단 자동화 시스템과 분석 장비를 기반으로 신속하고 정확하게 결과를 보고하여 드리며, 각 분야별 전문의가 결과를 판독하고 임상 자문 및 학술 연구를 통해 전문적인 검사 정보를 제공하여 진료에 도움을 드리고 있습니다.

임상화학
혈액, 소변, 체액을 포함한 다양한 검체의 화학적 성분을 측정하여 질병 진단과 치료 경과 관찰을 위한 정보를 제공합니다. 최신 자동화학분석기로 엄격한 정도관리를 통해 보다 신속하고 정밀한 결과를 제공합니다.
- 간기능
- 신장기능
- 전해질
- 혈당
- 지질
- 약물농도

요화학
소변의 물리적, 화학적 성상을 측정하여 신장 및 요로 질환의 병태 파악과 내분비 및 전신성 질환 진단에 도움을 주는 중요한 검사입니다. 최신 전자동화 요검사 통합장비로 신뢰성 있는 결과를 제공하고 있습니다.
- 요일반 검사
- 요침사 검사

혈액학
빈혈, 혈액 종양, 출혈 및 혈전 질환 등 혈액 관련 질환 진단에 필수적인 일반혈액, 골수검사, 혈액응고 검사, 당화혈색소 검사, 혈액은행검사 등을 수행하고 있습니다. 또한, 당화혈색소 검사(HbA1C)는 NGSP Level 1을 획득하여 정확한 검사 결과로 인증받고 있습니다.
- 일반혈액 검사
- 혈액응고 검사
- 골수 검사
- 수혈관련 검사

면역학
면역측정법(항원-항체 반응)을 이용하여 호르몬 정량 검사, 종양표지자 검사, 자가면역질환 검사, 알레르기 검사 및 각종 감염질환을 진단하기 위한 혈청학적 검사 등을 시행합니다. 면역자동화 시스템으로 검사 소요시간을 단축하여 신속한 검사결과를 제공하고 있습니다.
- 호르몬 정량 검사
- 종양표지자 검사
- 알레르기 검사
- 잠복결핵 검사
- 자가 항체 검사
- 림프구 아형 검사

핵의학
방사성 동위원소(radioisotope, RI)를 표지자로 사용하여 검사를 시행하며 고도의 숙련된 인력과 특수 설비를 갖춘 독립된 공간에서 다양한 내분비 검사 및 산전 기형아 선별 검사 등을 시행합니다.
- 산전 기형아 선별 검사
- 호르몬 특수 검사

특수화학
다양한 특수화학 장비를 이용하여 내분비 대사 관련 질환 등의 진단을 위해 선천성 대사 이상 선별검사, 카테콜라민 대사 관련 물질 검사, 중금속 분석, 단백질 분획 검사 등을 분석하고 있습니다. 숙련된 전문 인력과 최첨단 특수 설비 및 실험실을 구축하여 최신 사양의 특수분석 장비로 더욱 정밀한 검사 결과를 제공하고 있습니다.
- 대사체 분석
- 비타민, 중금속 분석
- 선천성 대사 이상 선별검사
- 전기영동
미생물학
인체 내 다양한 가검물로 감염 질환의 원인 병원체를 분리 및 동정하고 항균제 감수성 검사는 Clinical and Laboratory Standards Institute (CLSI) 지침에 따라 시행하여 정확하고 신속한 검사 결과를 제공하고 있습니다. 검사실 안전과 검체 오염 방지를 위한 전문 시설을 갖춘 독립된 공간을 보유하여 보다 안전하고 정밀한 검사를 수행하고 있습니다.
- 미생물 배양 및 동정, 항균제 감수성 검사
- 결핵 배양, 동정 검사
- 진균 검사
- 기생충 검사
- 분변잠혈 검사

분자미생물학
감염병 진단의 필수 시설인 오염 방지를 위한 최첨단 시설(이중문, 음압 시설, PCR room 등)을 갖춘 독립 공간에서 최신 분자 기술을 이용하여 세균 및 바이러스 감염 검사를 수행하고 있습니다.
- 코로나바이러스감염증-19 분자진단 검사
- HPV 유전자형 검사
- 성매개성 질환 분자진단 검사
- 호흡기 바이러스 검사
- 폐렴 원인균 선별검사
- HBV, HCV 정량 검사
- MTB&NTM 검사
- 결핵균 및 리팜핀 내성검사

분자유전학
최신 분자진단 방법을 이용하여 유전성 질환, 종양 관련 유전자, 이식 관련 유전자 검사 등 전문화된 유전자 검사를 수행하고 있으며, 고도의 전문화된 인력이 철저한 평가 과정을 거친 검사 관리로 정확도 높은 고품질 검사 결과를 제공하고 있습니다.
- 고형암, 희귀질환 유전자 패널 NGS 검사
- 암 유전자 검사(BRCA, EGFR, BRAF 등)
- 조직적합성 검사(HLA)

세포유전학
선천성 염색체 이상과 종양세포의 염색체 이상 등을 진단하기 위해 최첨단 자동화 핵형분석 시스템을 도입하여 염색체 핵형분석과 FISH Panel 검사 등 고품질의 세포유전학 검사 결과를 제공하고 있습니다.
- 염색체 검사
- FISH 검사

검체관리
검체의 정확한 분주 및 분류와 보관이 가능한 시스템을 구축하여, 검체가 검사실 내에서 정확하게 처리되고 신속하게 검사가 이뤄질 수 있도록 검사업무 전반을 관리합니다.
- 검체 분류 및 분주, 보관
- 검사 지원